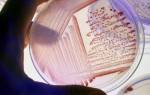

Помните, в детстве родители постоянно заставляли нас мыть руки. Иначе, говорили они, живот заболит. Наши мамы были правы, ведь не видимые глазу микроорганизмы могут стать причиной тяжелых заболеваний. А вот ученые выяснили, что возбудители инфекций наносят вред живому организму в разной степени. Микробиологи выделили отдельные группы патогенности микроорганизмов, такую классификацию предложила Всемирная организация здравоохранения. И используют ее во многих странах по всему миру.
Опасен или нет – вот в чем вопрос
Предложенный Всемирной организацией здравоохранения вариант классификации, исходя из уровня болезнетворности, широко используется в лицензионных лабораториях и состоит из четырех основных категорий:
- К первой группе патогенности классификации относят микробы, которые не несут ни индивидуальной, ни общественной опасности. Принято считать, что вероятность возникновения инфекции от контакта с представителями этой группы патогенности ничтожно мала.
- Ко второй группе отнесены бактерии, которые несут умеренный риск обществу. Они могут вызывать заболевания у отдельных индивидов, причиной часто является нарушение иммунитета. Например, язвенная болезнь 12-перстной кишки.
- К третьей группе по классификации относятся микроорганизмы, которые несут высокий индивидуальный риск, но незначительный общественный. Такие микробы вызывают тяжелые болезни, которые требуют специального медикаментозного лечения. Но «перепрыгивать» с одной живой особи на другую они не умеют. В качестве представителя третьей группы патогенности можно выделить Clostridium botulinum. По усвоению углерода он относится к гетеротрофам и вызывает тяжелую интоксикацию у жертвы, которая приводит к поражению нервной системы.
- Микробы четвертой группы особо опасны как для отдельных лиц, так и для общества в целом. Они приводят к тяжелым заболеваниям, которые очень сложно поддаются лечению. Инфекция легко циркулирует среди животных и людей, очень плохо поддается профилактике и становится виновником эпидемий. Чумная палочка стала поистине злым роком человечества, который уносил десятки тысяч жизней, опустошал деревни и города. Современная медицина научилась побеждать смертоносного врага с помощью антибиотиков.
Анализ на наличие микроорганизмов 3-4 групп проводят в специальных лабораториях, которые имеют лицензию на работу с опасными инфекциями, с соблюдением всех требований безопасности.
Врачи отмечают, что классификация микроорганизмов по патогенности является важным инструментом в медицинской практике. Она позволяет систематизировать микроорганизмы в зависимости от их способности вызывать заболевания у человека. Врачи выделяют несколько групп: патогенные, условно-патогенные и непатогенные микроорганизмы. Патогенные организмы, такие как бактерии и вирусы, способны вызывать острые инфекции, тогда как условно-патогенные могут стать причиной заболеваний только при определенных условиях, например, при ослаблении иммунной системы. Непатогенные микроорганизмы, как правило, не представляют угрозы для здоровья. Эта классификация помогает врачам в диагностике и выборе методов лечения, а также в профилактике инфекционных заболеваний. Правильное понимание патогенности микроорганизмов способствует более эффективному контролю за инфекциями и улучшению здоровья населения.

Два слагаемых одной опасности
Патогенность – общая черта всех возбудителей инфекционных болезней. Проще говоря, это способность микробов проникать внутрь животных и вызывать патологические изменения в тканях и органах.
Но нанести ощутимый вред способны только виды бактерий, которые обладают вирулентностью. Их агрессивные свойства настолько велики, что даже мизерное количество бактериальных клеток способно запустить инфекционный процесс. Единицей измерения вирулентности служат летальная и инфицирующая дозы, которые могут изменяться в зависимости от:
- массы животного;
- возраста особи;
- состояния иммунитета;
- способа попадания внутрь.
О степени вирулентности специалисты судят, анализируя тяжесть заболевания, а также его исход.
Еще одна система
Принятая учеными классификация утверждает, что по степени вирулентности болезнетворные бактерии делятся на 3 группы:
- патогенные:
- условно-патогенные;
- сапрофиты.
Начнем с микроскопических существ, которые безобидны для человека. Это сапрофиты. Питаются они субстратами из органических останков и замечательно обеспечивают себя пищей самостоятельно, не нанося вред другим живым организмам.
Порой сапрофиты оказывают человеку и животным неоценимую услугу по обеспечению их жизнедеятельности. Например, кишечная флора: она не только создает условия для пищеварения в кишечнике, но и укрепляет иммунитет.
https://youtube.com/watch?v=LXuVUYKUelM
К другой группе патогенности относятся условно-патогенные бактерии, которые обитают внутри живых организмов, абсолютно не оказывая на них пагубного влияния. Но коварство этих малышей состоит в том, что при снижении иммунитета они быстро становятся источником инфекции. Какие же факторы могут спровоцировать столь агрессивное поведение представителей этой группы? Это:
- прием алкоголя;
- табакокурение;
- тяжелые физические нагрузки;
- нервные стрессы.
Природа очень мудро устроила жизнь на Земле, предусмотрев возможность сосуществования столь различных по своей природе существ. Но при невыполнении условий для достижения нормального равновесия происходит массовая гибель полезных бактерий. И вот тогда условно-патогенные микробы становятся болезнетворными, проникают через тканевые барьеры и вызывают воспаление.
Условно-патогенными микробами, согласно классификации, являются стрептококки. В небольших количествах они встречаются в кишечнике животных. Стрептококки активизируют выработку иммуноглобулинов, поэтому причислить их к определенной группе патогенности микроорганизмов довольно сложно. Но, превратившись во врагов, они начинают стремительно делиться и провоцируют стрептококковые инфекции.
Самыми опасными для всего живого являются высоковирулентные микроорганизмы. Они могут вызывать опасные заболевания, даже попадая в организм в ничтожно малых дозах. Ученые считают, что бактериальные паразиты произошли от независимых сапрофитов, которые в процессе эволюции утратили необходимые ферментные системы и, соответственно, способность к самостоятельной жизни.
Как же выживают паразиты? Они кочуют от одного хозяина к другому. У каждого вида есть свои способы заражения живых организмов. А люди помогают им, пренебрегая соблюдением элементарной гигиены.
Классификация групп патогенности микроорганизмов по местам их обитания вызывает много обсуждений среди специалистов. Многие исследователи отмечают, что такая систематизация помогает лучше понять, как различные микроорганизмы взаимодействуют с окружающей средой и организмами-хозяевами. Например, патогенные бактерии, обитающие в кишечнике, могут вызывать заболевания, связанные с пищеварением, тогда как те, что находятся на коже, чаще становятся причиной инфекций.
Некоторые ученые подчеркивают важность учета не только патогенности, но и экологии микроорганизмов, их роли в поддержании баланса в экосистемах. Это позволяет разрабатывать более эффективные методы лечения и профилактики инфекционных заболеваний. В то же время, критики классификации указывают на необходимость гибкости в подходах, так как микроорганизмы могут менять свои свойства в зависимости от условий среды. Таким образом, обсуждение классификации остается актуальным и многогранным, открывая новые горизонты для исследований в области микробиологии и медицины.

Изучить и обезвредить
Болезнетворностью бактерии наделила сама природа. У патогенных организмов есть возможность вызывать аномальные изменения в тканях, и с этим человек ничего сделать не может.
Но повысить или понизить вирулентность искусственными методами человечеству под силу. В перечень таких приемов входит вакцинирование. Патогенные культуры длительное время выращивают вне живых организмов в специальных питательных растворах. А для ослабления факторов вирулентности к ним добавляют сулему, желчь, карболовую кислоту и т.д. Полученные таким образом вакцины используют в медицине и в сельском хозяйстве для профилактики инфекционных заболеваний.
Для изменения вирулентности патогенных микроорганизмов также используют:
- высушивание;
- воздействие солнечных лучей;
- пассирование — проведение инфекции от больного к здоровому организму через определенные виды животных;
- модификацию генотипа штамма.
Бактерии – старожилы на нашей планете, поэтому они отлично научились выживать в разных условиях. И люди часто являются для них лишь временным пристанищем. Но ценой такого знакомства с микробами может стать потеря здоровья, а порой и жизни. Какую бы классификацию ни придумали ученые, здоровье всегда находится в руках самого человека. Соблюдение личной гигиены, полноценное питание, отказ от вредных привычек значительно укрепят иммунитет. А у микроорганизмов, которые относятся к группам патогенности, останется очень мало шансов нанести вред.
Вопрос-ответ
Какова классификация патогенности микроорганизмов?
По степени биологической опасности микробы разделены на 4 группы патогенности: I группа – возбудители особо опасных инфекций, II группа – возбудители высококонтагиозных эпидемических заболеваний человека, III группа – возбудители инфекционных болезней, выделяемые в самостоятельные нозологические группы, IV группа.
Какие 5 типов патогенов существуют?
Заболевания могут вызывать самые разные микроорганизмы. Патогенные организмы делятся на пять основных типов: вирусы, бактерии, грибы, простейшие и глисты. Некоторые распространённые патогены каждой группы перечислены в колонке справа.
Каковы 4 основные группы патогенов человека?
Бактерии, вирусы, грибки и паразиты — всё это типы патогенов, которые могут вызывать как лёгкие, так и серьёзные проблемы со здоровьем при попадании в организм. Каждый из этих патогенов включает в себя множество подтипов, вызывающих широкий спектр инфекций и заболеваний.
Какие есть группы микроорганизмов?
Все микроорганизмы подразделяются на следующие группы: 1) бактерии, 2) грибки, 3) спирохеты, 4) простейшие, 5) риккетсии, 6) фильтрующиеся вирусы. Все они, за исключением некоторых грибков, представляют собой одноклеточные организмы.
Советы
СОВЕТ №1
Изучите основные группы патогенности микроорганизмов, чтобы понимать, какие из них представляют наибольшую угрозу для здоровья человека. Это поможет вам лучше ориентироваться в вопросах инфекционных заболеваний и профилактики.
СОВЕТ №2
Обратите внимание на факторы, влияющие на патогенность микроорганизмов, такие как вирулентность, устойчивость к антибиотикам и способность к образованию биопленок. Эти характеристики могут значительно повлиять на выбор методов лечения и профилактики.
СОВЕТ №3
Регулярно обновляйте свои знания о новых исследованиях и классификациях микроорганизмов, так как наука в этой области постоянно развивается. Это поможет вам оставаться в курсе актуальных угроз и методов борьбы с ними.
СОВЕТ №4
Не забывайте о важности личной гигиены и вакцинации, которые являются ключевыми мерами профилактики инфекционных заболеваний, связанных с патогенными микроорганизмами. Соблюдение этих простых правил может значительно снизить риск заражения.